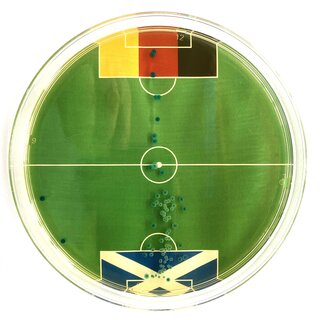

Das Bakterienorakel zeigt: Vor dem schottischen Tor wird es am 14. Juni Gedränge geben!
Forscher der Hochschule Furtwangen sagt EM-Ergebnisse voraus
Prof. Dr. Markus Egert ist begeistert: „Deutschland wird gegen Schottland gewinnen“, sagt er mit Überzeugung, und einem Augenzwinkern. Dazu schaut der renommierte Mikrobiologe, der an der Hochschule Furtwangen (HFU) lehrt, nicht in eine Kristallkugel – sondern in eine Petrischale. In einem nicht ganz ernst gemeinten „Bakterienorakel“ zur Fußball-EM tummelt sich eine Kultur harmloser Kolibakterien. Unter dem durchsichtigen Schalenboden hat Egert die Grafik eines kleinen Fußballfelds angebracht, mit Toren in beiden Landesfarben. Ganz klar: Im schottischen Torraum sind nach einer Brutzeit von wenigen Tagen wesentlich mehr Keime gewachsen als auf der deutschen Gegenseite.
Inspiriert wurde Fußballfan Egert von unterhaltsamen Orakeln wie etwa einem Oktopus, der Fußballergebnisse „vorhersagte“. „Man darf mit der eigenen Forschungsdisziplin auch mal ein bisschen Spaß haben“, sagt Egert, der als führender Hygieneprofessor in Deutschland ansonsten unter anderem Studien zur Keimbelastung von Haushaltsgegenständen führt. Für sein Orakel komme es darauf an, nur wenige Keime sehr gleichmäßig auf der Nährlösung zu verteilen, erklärt Egert. So kann das Wachstum genau beobachtet werden – in Form von Punkten, die dann in den beiden Spielhälften zu sehen sind. Für die Partie am 14. Juni gegen Schottland ist davon eine große Menge im schottischen 16-Meter-Raum zu sehen: „Da wird was los sein, das sieht gut aus“, lacht Egert.
Vor den Spieltagen der deutschen Nationalelf während der EM werden die Vorhersagen des HFU-Bakterienorakels auf den social media Kanälen der Hochschule veröffentlicht.